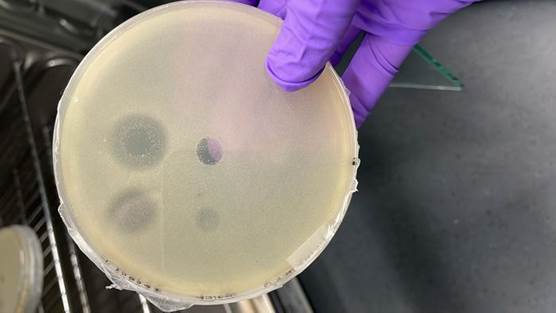

面對(duì)全球性的挑戰(zhàn),探索新型生物防御策略是當(dāng)前研究熱點(diǎn)之一。牛津大學(xué)與醫(yī)學(xué)研究委員會(huì)醫(yī)學(xué)科學(xué)實(shí)驗(yàn)室Tobias Warnecke團(tuán)隊(duì)在《PLOS Biology》期刊發(fā)表的研究表明,作為生命三域系統(tǒng)(古菌域、細(xì)菌域和真核生物域)重要組成部分的古細(xì)菌,具備開發(fā)新型生物活性物質(zhì)的潛力。

在微生物生存競(jìng)爭(zhēng)中,化學(xué)防御機(jī)制的進(jìn)化普遍存在。盡管現(xiàn)有生物活性物質(zhì)研究主要集中于細(xì)菌和真菌,但自然界中超過2萬種古細(xì)菌的防御系統(tǒng)尚未被系統(tǒng)探索。研究團(tuán)隊(duì)據(jù)此提出假設(shè):在細(xì)菌密集環(huán)境中生存的古細(xì)菌,可能進(jìn)化出獨(dú)特的防御機(jī)制。
圖片信息:喜鹽古細(xì)菌Halogranum salarium在Warnecke實(shí)驗(yàn)室的培養(yǎng)皿上生長(zhǎng)。該古細(xì)菌分泌的蛋白質(zhì)對(duì)一種喜鹽細(xì)菌(Halalkalibacterium halodurans)產(chǎn)生了抑制效應(yīng)。
通過分析3700余種古細(xì)菌基因組,研究人員重點(diǎn)篩選了編碼肽聚糖水解酶的基因。這類能切割肽聚糖的蛋白質(zhì)在古細(xì)菌中廣泛存在,且多數(shù)物種具備多種類型的防御系統(tǒng)。實(shí)驗(yàn)驗(yàn)證表明,部分古細(xì)菌來源的蛋白質(zhì)可有效抑制特定細(xì)菌的生長(zhǎng)。結(jié)構(gòu)分析證實(shí)這些蛋白質(zhì)具有胞外分泌特性,某些古細(xì)菌甚至擁有類似注射器的蛋白質(zhì)遞送系統(tǒng)。

圖片信息:肽聚糖水解酶(細(xì)菌素/古細(xì)菌素同源物)在細(xì)菌和古細(xì)菌中的分布
研究負(fù)責(zé)人Warnecke指出:“作為生命三域之一的古細(xì)菌,其生態(tài)交互機(jī)制研究尚未充分探索。”
項(xiàng)目首席科學(xué)家Romain Strock補(bǔ)充道:“傳統(tǒng)觀點(diǎn)認(rèn)為古細(xì)菌主要作為極端環(huán)境中的共生體存在,我們的發(fā)現(xiàn)揭示了其生存策略中競(jìng)爭(zhēng)性互動(dòng)的新層面。”該研究不僅拓展了微生物相互作用的理論認(rèn)識(shí),也為探索新型生物活性物質(zhì)提供了系統(tǒng)性的研究途徑。
期刊:PLOS Biology